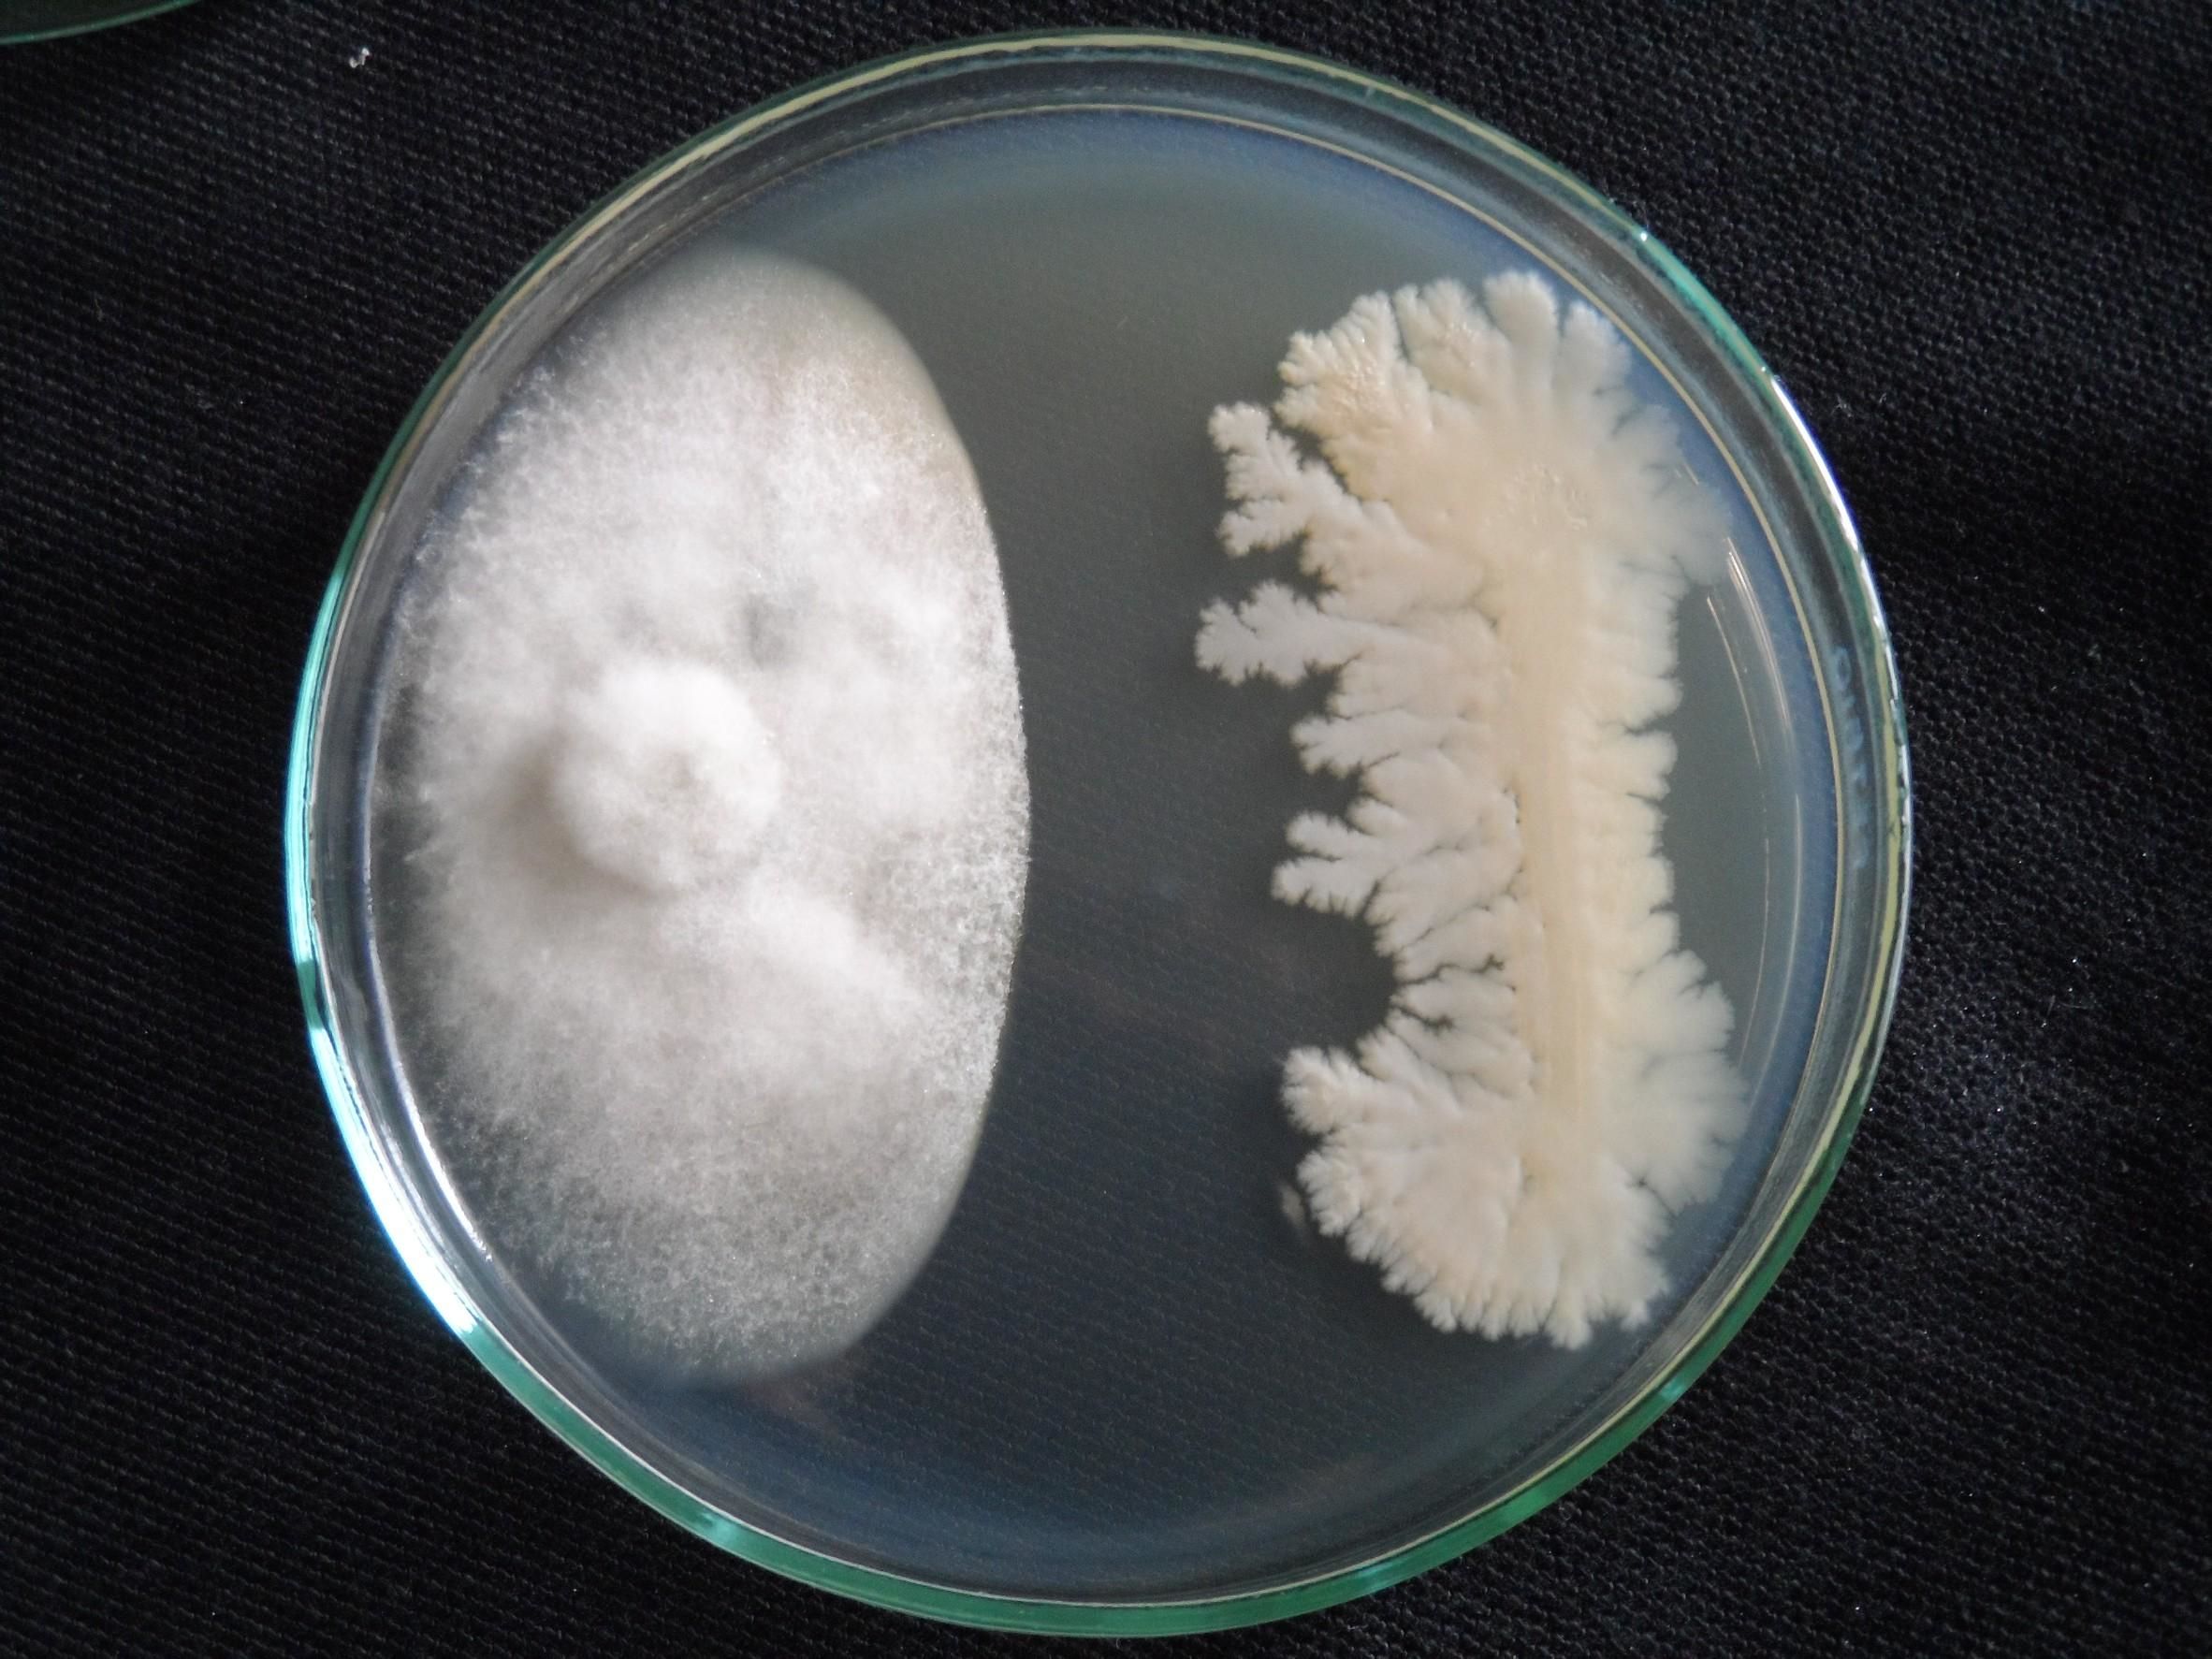
บีเอส-ดีโอเอ19W6 ทางเลือกที่ปลอดภัยในการควบคุมโรคแอนแทรกโนสพริก 2 918740

โรคแอนแทรกโนสหรือที่เกษตรกรเรียกว่าโรคกุ้งแห้งพริกเป็นปัญหาสำคัญที่ทำให้เกิดความเสียหายมากที่สุดต่อการปลูกพริกของเกษตรกรทั่วทุกภาคโดยเฉพาะในเขตภาคตะวันออกเฉียงเหนือตอนบน เนื่องจากเป็นโรคที่สามารถเข้าทำลายต้นพริกได้ทุกระยะการเจริญเติบโตทั้งต้น ใบ ดอก และผลพริก อาจทำความเสียหายแก่ผลผลิตทั้งก่อนและหลังเก็บเกี่ยวสูงถึง 80 เปอร์เซ็นต์ ทำให้เกษตรกรต้องใช้สารเคมีฉีดพ่น บ่อยครั้ง จนทำให้มีสารเคมีตกค้างบนผลผลิต สำนักวิจัยและพัฒนาการเกษตร เขตที่ 3 จึงนำเชื้อแบคทีเรีย Bacillus spp. จำนวน 13 สายพันธุ์ มาทดสอบประสิทธิภาพในการควบคุมเชื้อรา Colletotrichum สาเหตุของโรคแอนแทรกโนสพริก จนพบว่า เชื้อ B. subtilis สายพันธุ์ ดีโอเอ19W6 ซึ่งเป็นสายพันธุ์ที่ได้รับจากสำนักวิจัยพัฒนาการอารักขาพืช มีประสิทธิภาพดีที่สุด สามารถขยายได้ง่าย มีวิธีการที่ไม่ยุ่งยาก วัสดุอุปกรณ์สามารถหาได้ง่าย และต้นทุนต่ำ เกษตรกรสามารถขยายเชื้อเองได้ ประกอบด้วย หัวเชื้อ บีเอส-ดีโอเอ19W6 นมโคยูเอชที (นม UHT) รสจืดยี่ห้อใดก็ได้ เข็มฉีดยาขนาดเบอร์ 25 กระบอกฉีดยาขนาด 5 มิลลิลิตร และสก็อตเทปใส วิธีการผลิตขยายให้แกะฝากล่องนมบริเวณด้านข้างให้ยืดขึ้นเป็นรูปสามเหลี่ยม จากนั้นนำเข็มฉีดยาต่อกับกระบอกฉีด แล้วดูดหัวเชื้อบีเอส-ดีโอเอ19W6 ปริมาตร 2 มิลลิลิตร จากขวดหัวเชื้อและฉีดลงในนมกล่องขนาด 200 มิลลิลิตร (1 กล่อง) ตรงบริเวณกระดาษฟอยล์สีเงิน สำหรับแทงหลอดดูด แล้วจึงใช้สกอตซ์เทปใสปิดทับบริเวณรอยที่ฉีดหัวเชื้อลงไป เพื่อป้องกันการปนเปื้อนจากเชื้อจุลินทรีย์ชนิดอื่น นำไปเก็บไว้ที่อุณหภูมิห้องเป็นเวลา 1 วัน เพื่อให้เชื้อแบคทีเรียขยายเพิ่มปริมาณในนม ก่อนจะนำไปใช้ หากใช้ไม่หมดสามารถเก็บไว้ได้ 12 วัน ที่อุณหภูมิห้อง ส่วนเข็มฉีดยาที่ใช้แล้วสามารถนำกลับมาใช้ใหม่ได้โดยก่อนเก็บไว้ใช้ให้นำไปต้มในน้ำเดือดประมาณ 5 นาที และก่อนนำมาใช้ในครั้งต่อไปให้ต้มในน้ำเดือดอีกประมาณ 5 นาที

วิธีการใช้ชีวภัณฑ์ บีเอส-ดีโอเอ19W6 ป้องกันกำจัดโรคกุ้งแห้งพริก โดยนำชีวภัณฑ์ บีเอส-ดีโอเอ19W6 ที่ขยายในนม อัตรา 100 มิลลิลิตร ผสมน้ำ 20 ลิตร และสารจับใบ (อัตราตามคำแนะนำข้างฉลาก) ฉีดพ่นในระยะกล้า ตั้งแต่ต้นกล้าเริ่มมีใบจริง (อายุประมาณ 10 วัน หลังเพาะ) และพ่นซ้ำทุก 7 วัน จนกว่าจะย้ายปลูก และหลังย้ายปลูกในระยะที่พริกออกดอกและเริ่มติดผลเขียว พ่นทุก 7 วัน จนกว่าจะเก็บผลผลิตหมด ควรพ่นตอนเย็นเพื่อหลีกเลี่ยงความร้อนจากแสงแดด และพ่นให้ทั่วทั้งต้นจนเปียก

“ชีวภัณฑ์ บีเอส- ดีโอเอ19W6 สามารถควบคุมโรคกุ้งแห้งพริกได้อย่างมีประสิทธิภาพทำให้การระบาดของโรคลดลงกว่า 60 เปอร์เซ็นต์ ที่สำคัญคือสามารถผลิตขยายได้ง่ายในนมกล่อง ใช้ต้นทุนต่ำเพียงไร่ละประมาณ 250-400 บาท/ฤดูปลูก โดยเชื้อที่ขยายในนม 2 กล่องผสมน้ำ 80 ลิตร ฉีดพ่นพริกได้จำนวน 1 ไร่ และพ่นต่อเนื่อง 14 -20 ครั้ง สามารถเก็บผลผลิตได้มากถึง 5 รุ่น ซึ่งหากมีโรคกุ้งแห้งพริกระบาดเกษตรกรจะเก็บผลผลิตได้ไม่เกิน 2 รุ่น ทำให้เกษตรกรมีรายได้สุทธิเพิ่มขึ้น 12.5 เปอร์เซ็นต์ โดยที่ผ่านมา สำนักวิจัยและพัฒนาการเกษตร เขตที่ 3 ได้ผลิตและกระจายหัวเชื้อให้เกษตรกรได้นำไปใช้ป้องกันกำจัดโรคกุ้งแห้งพริกแล้วในจังหวัดขอนแก่น กาฬสินธุ์ ชัยภูมิ และนครพนม เกษตรกรที่ประสบปัญหาการระบาดของโรคกุ้งแห้งพริกสามารถสอบถามรายละเอียดเพิ่มเติมได้ที่ สำนักวิจัยและพัฒนาการเกษตร เขตที่ 3 กรมวิชาการเกษตร โทรศัพท์ 043-203500 ต่อ 292”







